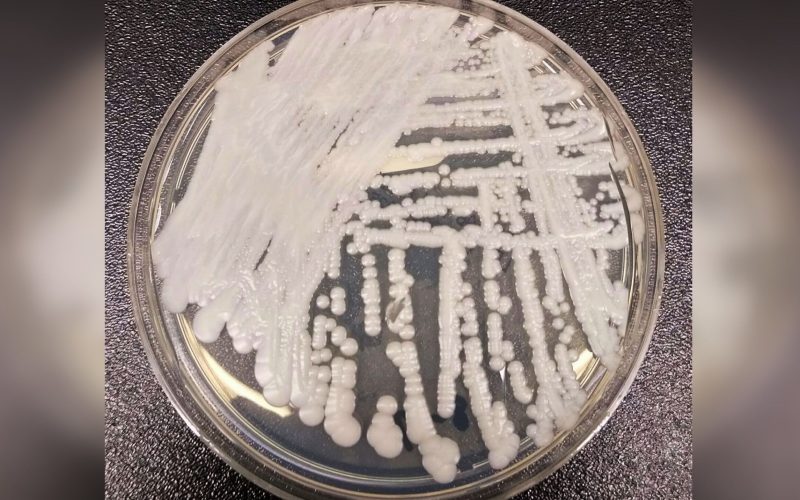
Candida Auris, coșmarul spitalelor, endemică și în România

Ciuperca Candida auris, o amenințare la adresa sănătății publice, a devenit endemică în cinci țări europene, inclusiv România, potrivit unei analize recente. Studiul, publicat în Clinical Microbiology and Infection, atrage atenția asupra răspândirii acestei infecții fungice periculoase în unitățile medicale. Italia, Spania, Grecia, România și Regatul Unit sunt acum considerate zone endemice pentru Candida auris.
Creștere alarmantă a cazurilor în Europa
Între 2013 și 2023, autoritățile sanitare europene au raportat peste 4.000 de cazuri de colonizare sau infecție cu Candida auris. Din 2020, s-a observat o creștere dramatică a numărului de cazuri. Ciuperca prezintă un risc major pentru pacienții cu stare critică și pentru cei imunocompromiși, de multe ori fiind rezistentă la tratamentele antifungice standard, cum ar fi fluconazolul.
Nicholas Geremia, specialist în boli infecțioase din Veneția, a subliniat dificultățile pe care le ridică rezistența ciupercii la mediul spitalicesc în ceea ce privește controlul infecțiilor. Capacitatea ciupercii de a supraviețui pe suprafețele din spitale și de a rezista la dezinfectanții obișnuiți reprezintă o amenințare constantă. Echinochinele rămân o terapie eficientă de primă linie.
Factori favorabili răspândirii și impactul asupra grupurilor vulnerabile
Răspândirea globală a Candida auris, identificată inițial în Japonia în 2009, este asociată cu diverși factori, inclusiv schimbările climatice și numărul crescut de pacienți vulnerabili în urma pandemiei de COVID-19. În Africa de Sud, aceasta este a doua cauză principală de candidemie care pune viața în pericol.
Nelesh Govender, profesor la Universitatea din Witwatersrand, avertizează asupra impactului sever asupra unităților de neonatologie. „Nou-născuții prematuri au bariere hematoencefalice atât de imature încât, atunci când C. auris pătrunde în fluxul sanguin, poate ajunge direct în creier,” a punctat medicul.
Măsuri de control și perspective de viitor
În ciuda riscurilor, unii experți consideră că amenințarea poate fi gestionată prin screening riguros și cooperare multidisciplinară. Matteo Bassetti, director clinic la Spitalul Universitar San Martino din Genova, a raportat eliminarea cu succes a cazurilor de candidemie din unitatea sa până în 2024, prin protocoale stricte de izolare și curățare.
Bassetti a menționat că, deși situația este gravă, rata mortalității este comparabilă cu cea a altor specii de Candida, deoarece există în continuare opțiuni de tratament eficiente. El a atribuit succesul lor unei strategii de colaborare care a implicat specialiști, microbiologi și asistente medicale.
Un articol despre această ciupercă, intitulat „Ciuperca Candida auris este acum endemică în cinci state din Europa, inclusiv România. Poate fi ținută sub control?” a fost publicat recent.
Sursa: Go4IT